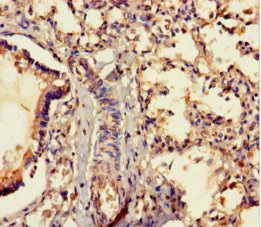

MRAP2 Antibody
-
中文名稱:MRAP2兔多克隆抗體
-
貨號:CSB-PA853421LA01HU
-
規格:¥440
-
圖片:
-
Western blot
All lanes: MRAP2 antibody at 7µg/ml
Lane 1: Mouse brain tissue
Lane 2: Mouse kidney tissue
Secondary
Goat polyclonal to rabbit IgG at 1/10000 dilution
Predicted band size: 24 kDa
Observed band size: 24 kDa -
Immunofluorescent analysis of U251 cells using CSB-PA853421LA01HU at dilution of 1:100 and Alexa Fluor 488-congugated AffiniPure Goat Anti-Rabbit IgG(H+L)
-
Immunohistochemistry of paraffin-embedded human lung tissue using CSB-PA853421LA01HU at dilution of 1:100
-
Immunohistochemistry of paraffin-embedded human brain tissue using CSB-PA853421LA01HU at dilution of 1:100
-
-
其他:
產品詳情
-
產品名稱:Rabbit anti-Homo sapiens (Human) MRAP2 Polyclonal antibody
-
Uniprot No.:
-
基因名:MRAP2
-
別名:MRAP2; C6orf117; Melanocortin-2 receptor accessory protein 2; MC2R accessory protein 2
-
宿主:Rabbit
-
反應種屬:Human, Mouse
-
免疫原:Recombinant Human Melanocortin-2 receptor accessory protein 2 protein (66-205AA)
-
免疫原種屬:Homo sapiens (Human)
-
標記方式:Non-conjugated
本頁面中的產品,MRAP2 Antibody (CSB-PA853421LA01HU),的標記方式是Non-conjugated。對于MRAP2 Antibody,我們還提供其他標記。見下表:
-
克隆類型:Polyclonal
-
抗體亞型:IgG
-
純化方式:>95%, Protein G purified
-
濃度:It differs from different batches. Please contact us to confirm it.
-
保存緩沖液:Preservative: 0.03% Proclin 300
Constituents: 50% Glycerol, 0.01M PBS, PH 7.4 -
產品提供形式:Liquid
-
應用范圍:ELISA, WB, IHC, IF
-
推薦稀釋比:
Application Recommended Dilution WB 1:1000-1:5000 IHC 1:20-1:200 IF 1:50-1:200 -
Protocols:
-
儲存條件:Upon receipt, store at -20°C or -80°C. Avoid repeated freeze.
-
貨期:Basically, we can dispatch the products out in 1-3 working days after receiving your orders. Delivery time maybe differs from different purchasing way or location, please kindly consult your local distributors for specific delivery time.
-
用途:For Research Use Only. Not for use in diagnostic or therapeutic procedures.
相關產品
靶點詳情
-
功能:Modulator of melanocortin receptor 4 (MC4R), a receptor involved in energy homeostasis. Plays a central role in the control of energy homeostasis and body weight regulation by increasing ligand-sensitivity of MC4R and MC4R-mediated generation of cAMP. May also act as a negative regulator of MC2R: competes with MRAP for binding to MC2R and impairs the binding of corticotropin (ACTH) to MC2R. May also regulate activity of other melanocortin receptors (MC1R, MC3R and MC5R); however, additional evidence is required in vivo.
-
基因功能參考文獻:
- The accepted idea that melanocortin Receptor Accessory Proteins (MRAPs) are specific regulators of melanocortin receptors was recently challenged by the discovery that MRAP2 inhibits the activity of prokineticin receptors. Recent studies are starting to explain the role of the unusual structure of MRAPs and to illustrate the importance of MRAP2 for the maintenance of both energy and glucose homeostasis. [review] PMID: 28499989
- In this study we demonstrate a new role of MRAP2 in the regulation of the orexin receptor 1 (OX1R) and identify the specific regions of MRAP2 required for the regulation of OX1R and PKR1. Importantly, like MC4R and PKRs, OX1R is predominately expressed in the brain where it regulates food intake PMID: 28939058
- This was the first study describing an effect of a MRAP2 mutation on mediated by regulation of the melanocortin-4 receptor FUNCTION IN HUMAN. PMID: 27474872
- no gene harboring deletions were identified in the SIM1 and MRAP2 regions in the Prader Willi like (PWL) cohort; further functional analysis of p.P352S found in SIM1 and p.A40S found in MRAP2 is useful; this would provide further support for possible role of SIM1 and MRAP2 in the pathogenesis of the PWL phenotype in a limited number of patients PMID: 26795956
- MC3R is a 2-exon gene that requires a 5' UTR for translation, localization, and potential interaction with MRAP2 PMID: 25051171
- In a study of humans with severe, early-onset obesity, they found four rare, potentially pathogenic genetic variants in MRAP2, suggesting that the gene may also contribute to body weight regulation in humans. PMID: 23869016
- Data suggest that MRAP2 regulates expression of melanocortin receptors (MC1R-MC5R); MRAP2 is highly expressed in fetal adrenal glands; MRAP2 is also expressed in hypothalamus, a site that expresses high levels of MC3R and MC4R. [REVIEW] PMID: 23418361
- MRAP2 is positively regulated by ACTH and AngII in human adrenocortical tissues. PMID: 22419722
- The MC2R/MRAP2 complex requires much higher concentrations of ACTH to activate compared with the MC2R/MRAP complex. PMID: 21367968
- MRAP2 is an endogenous inhibitor that competes with MRAP for binding to MC2R and decreases the potency of adrenocorticotropic hormone (ACTH). PMID: 20371771
顯示更多
收起更多
-
相關疾病:Obesity (OBESITY)
-
亞細胞定位:Cell membrane; Single-pass membrane protein. Endoplasmic reticulum membrane; Single-pass membrane protein.
-
蛋白家族:MRAP family
-
組織特異性:Expressed in the adrenal gland and brain. Not expressed in other tissues.
-
數據庫鏈接:
Most popular with customers
-
YWHAB Recombinant Monoclonal Antibody
Applications: ELISA, WB, IHC, IF, FC
Species Reactivity: Human, Mouse, Rat
-
Phospho-YAP1 (S127) Recombinant Monoclonal Antibody
Applications: ELISA, WB, IHC
Species Reactivity: Human
-
-
-
-
-
-